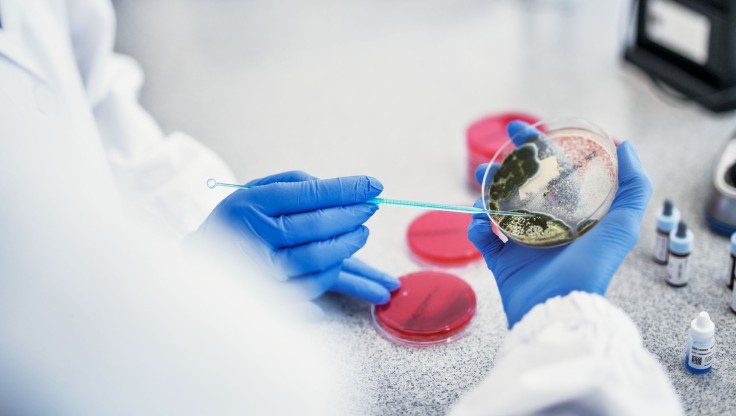

Studieren um Biomedizinische:r Labortechniker:in zu werden
Biomedizinische Labortechniker:innen sind Spezialist:innen in der Durchführung und Auswertung chemischer und mikroskopischer Laboruntersuchungen. Dabei führen sie verschiedenste Messungen und Untersuchungen an Körperflüssigkeiten, Geweben und Zellen durch und erstellen Befunde, die die Grundlage für die Diagnose, Verlaufskontrolle und Therapie von Krankheiten bilden.